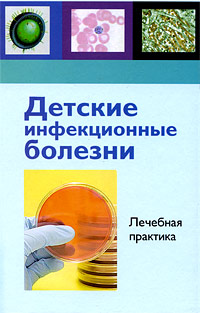

18+
На сайте представлено только описание и выходные данные книги «Детские инфекционные болезни. Лечебная практика ». Сайт не является распространителем книги. Сайт не предоставляет возможности купить, читать онлайн или скачать бесплатно книгу «Детские инфекционные болезни. Лечебная практика ». Сайт предназначен для лиц старше 18 лет. Если вам не исполнилось 18 лет - незамедлительно покиньте сайт. Оставаясь на сайте вы подтверждаете, что вам исполнилось 18 лет.
Незаконное потребление наркотических средств, психотропных веществ, их аналогов причиняет вред здоровью, их незаконный оборот запрещен и влечет установленную законодательством ответственность
Учебное пособие подготовлено сотрудниками кафедры инфекционных болезней с курсом детских инфекций УО "ГрГМУ" и кафедры детских инфекций УО "БГМУ", для студентов педиатрических факультетов в соответствии с требованиями типовой программы, инструктивно-руководящих документов органов здравоохранения Беларуси и на основании современных представлений медицинской науки. Учебное пособие является своего рода руководством для студентов к практическим занятиям в детской инфекционной клинике. Оно содержит сведения, которыми должен овладеть студент по разделу типовой программы: умения и навыки, ситуационные задачи и тестовый контроль 1 и 2 уровня.
Информация, изложенная в нем, может быть использована в практической деятельности педиатрами, инфекционистами, врачами общей практики (семейными врачами) и др. Это и многое другое вы найдете в книге Детские инфекционные болезни. Лечебная практика
| Полное название книги | Детские инфекционные болезни. Лечебная практика |
| Тип | Книга |
| Автор | |
| Категории | Для техникумов и вузов, Образование и наука, Книги |
| ISBN | 9789856711469 |
| Возрастное ограничение | 18 |
| Издательство | Асар |
| Год | 2009 |
| Название транслитом | detskie-infekcionnye-bolezni-lechebnaya-praktika |
| Просмотров | 1 |
| Рейтинг izbe.ru | 0,0 |

Мари Мур

Брук Лин

Конкордия Антарова

Дэниел Киз

Абрахам Вергезе

Аида Синицына

Вадим Зеланд

Сергей Лукьяненко

Роберт Грин

Виктор Дашкевич

Роман Прокофьев

Пауло Коэльо